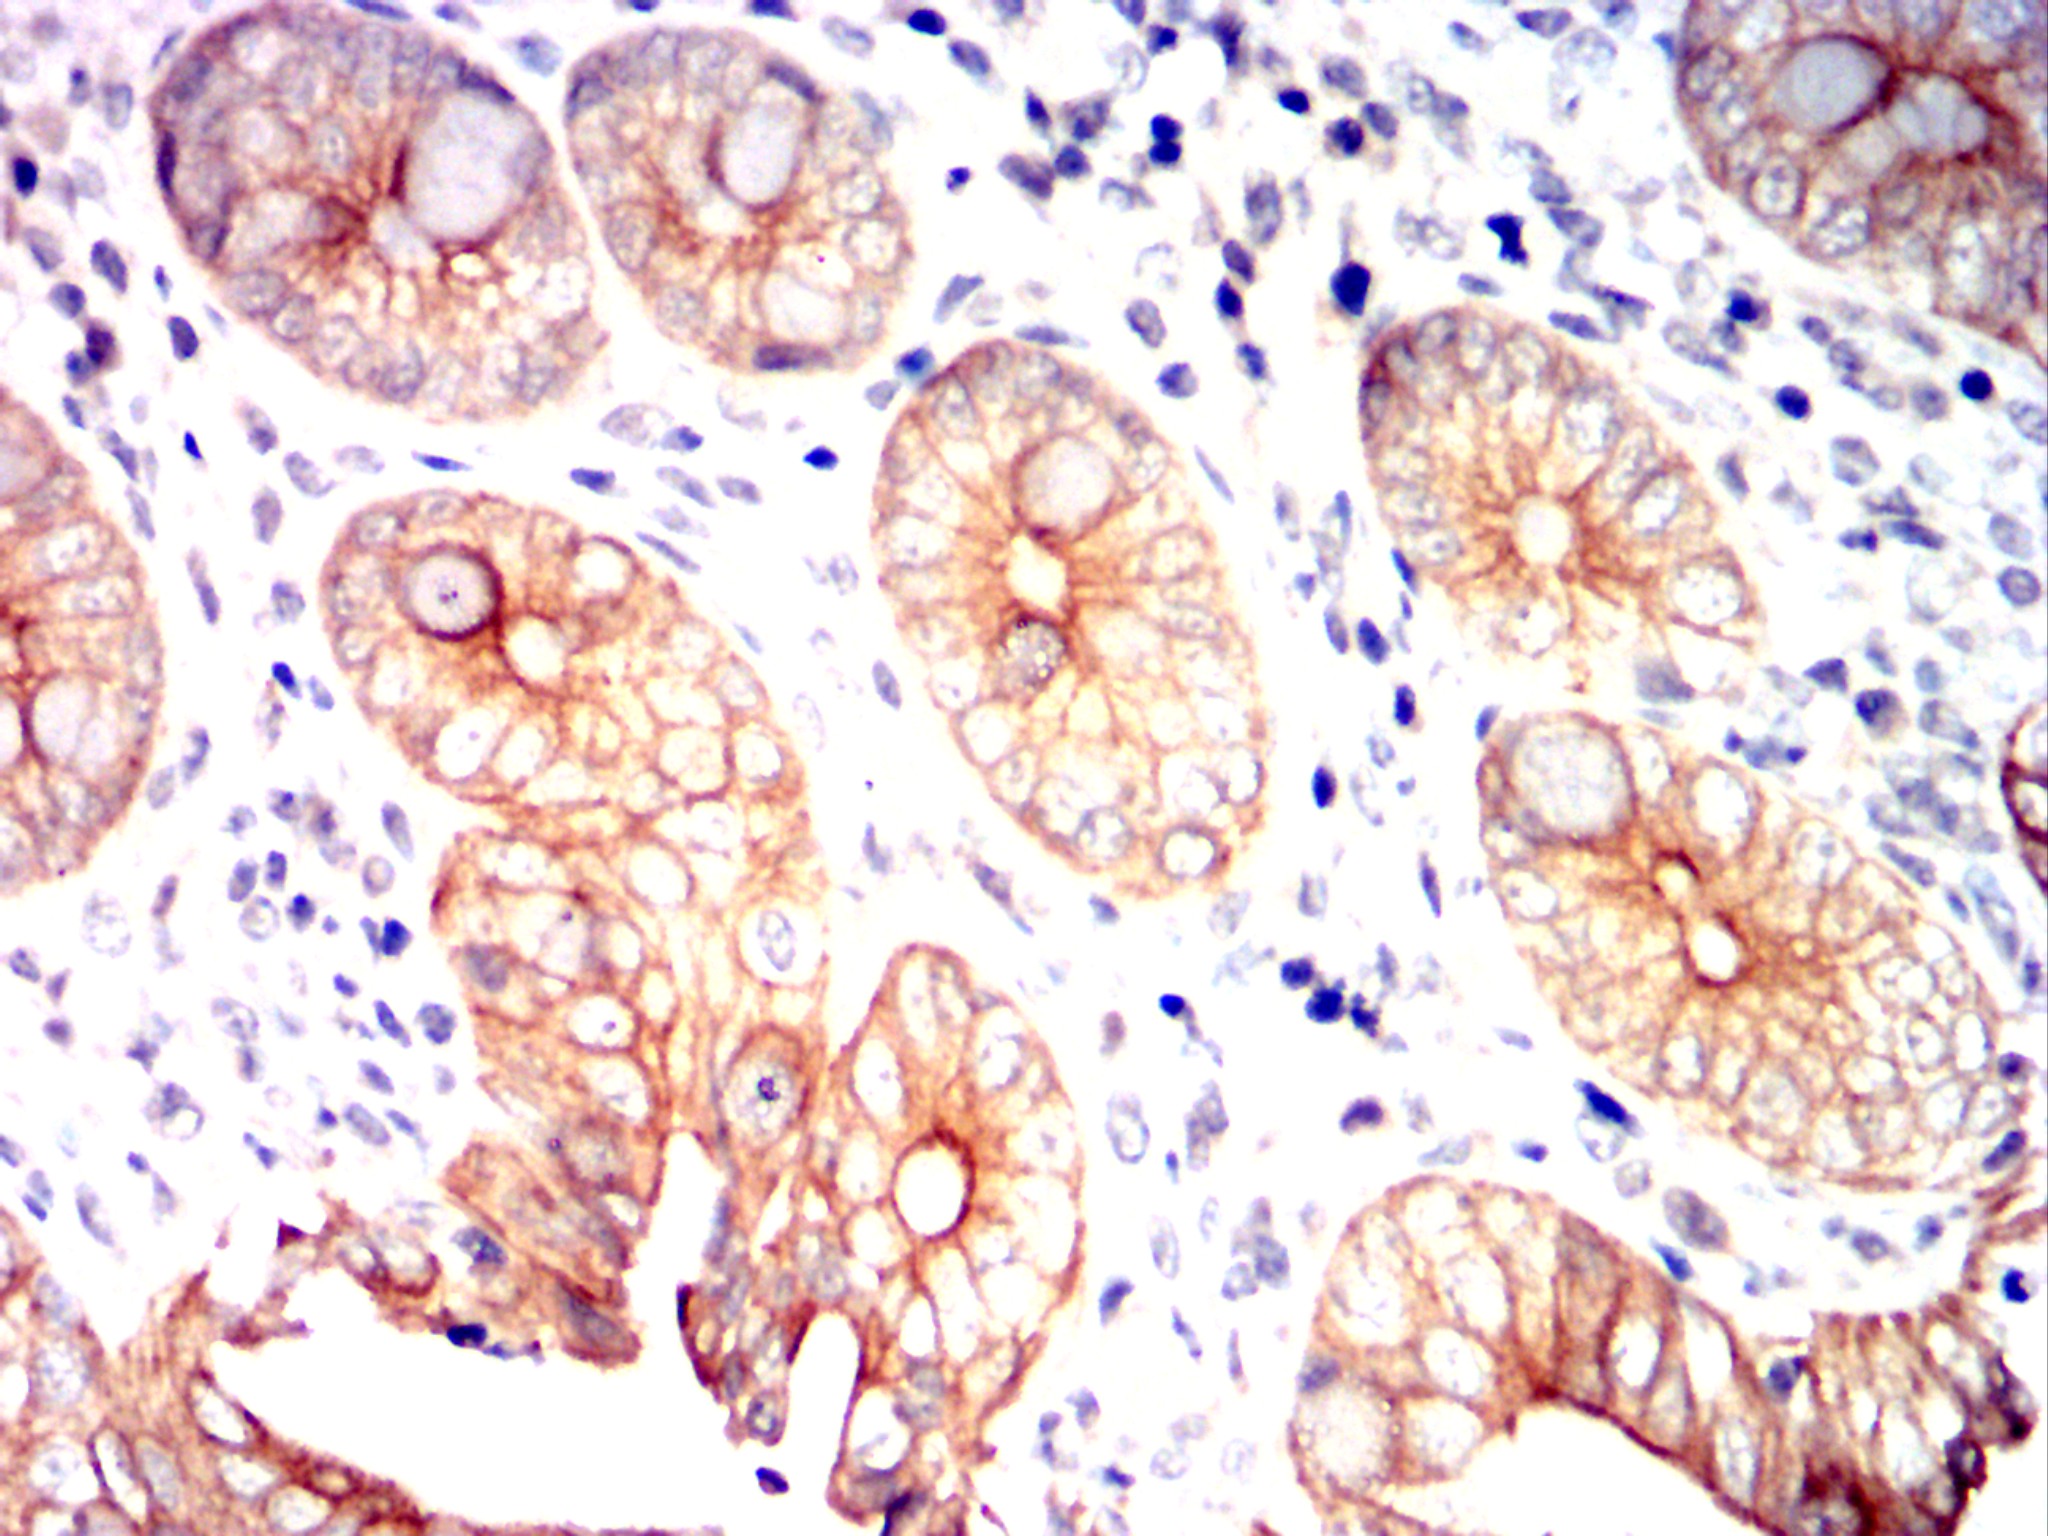

Mouse Monoclonal Antibody to EIF2AK2
货号:
30680
别名:
PKR; PRKR; EIF2AK1
应用:
WB,IHC,FCM
反应种属:
Human,Mouse,Rat,Rabbit
抗体类型:
Primary antibody
Swissprot:
P19525
规格:
目录价
在线咨询
Description |
|---|
The protein encoded by this gene is a serine/threonine protein kinase that is activated by autophosphorylation after binding to dsRNA. The activated form of the encoded protein can phosphorylate translation initiation factor EIF2S1, which in turn inhibits protein synthesis. This protein is also activated by manganese ions and heparin. Three transcript variants encoding two different isoforms have been found for this gene. |
References |
|---|
| 1. J Alzheimers Dis. 2010;21(4):1217-31. 2. Mol Cells. 2011 Aug;32(2):167-72. |
Specification |
|
|---|---|
| Aliases | PKR; PRKR; EIF2AK1 |
| Entrez GeneID | 5610 |
| Swissprot | P19525 |
| clone | 6H3A10 |
| WB Predicted band size | 62kDa |
| Host/Isotype | Mouse IgG1 |
| Antibody Type | Primary antibody |
| Storage | Store at 4°C short term. Aliquot and store at -20°C long term. Avoid freeze/thaw cycles. |
| Species Reactivity | Human,Mouse,Rat,Rabbit |
| Immunogen | Purified recombinant fragment of human EIF2AK2 (AA: 329-551) expressed in E. Coli. |
| Formulation | Purified antibody in PBS with 0.05% sodium azide. |
Application |
|
|---|---|
| WB | 1/500 - 1/2000 |
| IHC | 1/100 - 1/500 |
| FCM | 1/200 - 1/400 |
| ELISA | 1/10000 |
Product Image
-
Black line: Control Antigen (100 ng); Purple line: Antigen(10ng); Blue line: Antigen (50 ng); Red line: Antigen (100 ng);

-
Western blot analysis using EIF2AK2 mouse mAb against A431 (1), THP-1 (2), MCF-7 (3), PC-12 (4) cell lysate.

-
Flow cytometric analysis of A431 cells using EIF2AK2 mouse mAb (green) and negative control (red).

-
Immunohistochemical analysis of paraffin-embedded human cervical cancer tissues using EIF2AK2 mouse mAb with DAB staining.

-
Immunohistochemical analysis of paraffin-embedded human rectum cancer tissues using EIF2AK2 mouse mAb with DAB staining.

-
Immunohistochemical analysis of paraffin-embedded Rabbit kidney using EIF2AK2 mouse mAb with DAB staining.

-
Immunohistochemical analysis of paraffin-embedded Rabbit rectum using EIF2AK2 mouse mAb with DAB staining.

鄂公网安备42018502007531号
鄂公网安备42018502007531号

